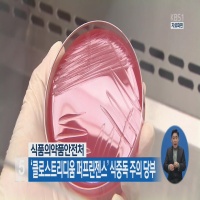

식중독은 전 세계적으로 흔한 건강 문제이며 오염된 음식이나 물을 섭취함으로써 발생합니다. 식중독을 일으키는 다양한 병원체 중에서 클로스트리디움 퍼프린젠스는 식중독의 중요한 세균성 원인입니다. 이 박테리아는 환경에 널리 퍼져 있으며 토양, 먼지 및 인간과 동물의 대변에 존재합니다. 음식을 오염시키면 클로스트리디움 퍼프린젠스 식중독을 일으켜 심각한 위장 증상을 일으킬 수 있다. 이 블로그 게시물에서는 클로스트리디움 퍼프린젠스 식중독의 원인, 증상, 예방 및 치료에 대해 논의합니다.
1.클로스트리디움 퍼프린젠스란?
클로스트리디움 퍼프린젠스(Clostridium perfringens)는 토양, 먼지, 인간과 동물의 장관에서 흔히 발견되는 그람 양성 혐기성 세균입니다. 가스 괴저, 봉와직염, 식중독 등 다양한 감염을 일으키는 것으로 알려져 있습니다.
C. perfringens는 포자 형성 박테리아로, 장기간 환경에서 휴면 상태로 생존할 수 있는 견고하고 저항성 있는 포자를 생성할 수 있습니다. 이 포자는 또한 고온, 낮은 pH 수준, 소독제의 존재와 같은 가혹한 조건에서도 살아남을 수 있어 파괴하기 어렵습니다.
C. perfringens에는 여러 종류의 독소 생산에 따라 A에서 E로 표시된 여러 유형이 있습니다. A형 균주는 C. perfringens 장독소(CPE)라는 내열성 독소를 생성하기 때문에 C. perfringens 식중독의 가장 흔한 원인입니다. 이 독소는 오염된 음식을 섭취한 후 6~24시간 이내에 복부 경련 및 설사와 같은 심각한 위장 증상을 유발할 수 있습니다.
식중독 외에도 C. perfringens는 조직 괴사 및 사지 절단으로 이어질 수 있는 심각한 상태인 가스 괴저, 심한 복통 및 사지 절단을 유발할 수 있는 소장의 염증인 괴사성 장염과 같은 다른 감염을 일으킬 수 있습니다. 설사.
2.클로스트리디움 퍼프린젠스 식중독의 위험 요인은 무엇입니까?
클로스트리디움 퍼프린젠스 식중독은 박테리아와 그 독소로 오염된 음식을 섭취함으로써 발생합니다. 다음은 씨. 퍼프린젠스 식중독 발병 가능성을 높일 수 있는 몇 가지 위험 요소입니다.
1.부적절한 식품 취급: C. 퍼프린젠스 박테리아는 흙, 물, 사람과 동물의 장에서 흔히 발견됩니다. 적절한 위생 관행을 따르지 않는 것과 같이 비위생적인 조건에서 식품을 준비하거나 취급하는 경우 C. perfringens에 오염될 위험이 더 높습니다.
2.대량 조리 및 보관: C. 퍼프린젠스 포자는 고온에서 생존할 수 있으며 20°C ~ 50°C(68°F ~ 122°F)의 온도에서 조리 및 보관된 식품에서 빠르게 성장하여 독소를 생성할 수 있습니다. 이것이 케이터링이나 뷔페 스타일 설정과 같이 많은 양의 음식을 요리하고 보관하는 것이 C. perfringens 식중독의 위험을 증가시킬 수 있는 이유입니다.
3.부적절한 조리: 음식을 권장 내부 온도로 조리하지 않으면 박테리아가 생존하고 성장하여 C. perfringens로 오염될 위험이 높아질 수 있습니다.
4.조리된 음식 재가열: 조리된 음식을 권장 내부 온도로 재가열하지 않으면 C. perfringens를 포함하여 존재할 수 있는 박테리아가 생존하고 성장하여 오염 위험이 증가할 수 있습니다.
5.육류 및 가금류 소비: C. 퍼프린젠스는 일반적으로 날고기 및 덜 익힌 육류 및 가금류에서 발견되며 이러한 식품은 가공 또는 취급 중에 오염될 수 있습니다.
6.연령 및 건강 상태: 노인과 면역 체계가 약한 사람들은 C. perfringens 식중독에 걸릴 위험이 더 높으며 더 심각한 증상을 경험할 수 있습니다.
7.음식 유형: C. perfringens 식중독은 일반적으로 스튜, 그레이비, 캐서롤과 같이 대량으로 준비되고 따뜻한 온도에서 장기간 보관되는 육류 요리의 소비와 관련이 있습니다.
3.클로스트리디움 퍼프린젠스는 어떻게 식중독을 유발합니까?
Clostridium perfringens는 오염된 식품에서 C. perfringens enterotoxin(CPE)이라는 내열성 독소를 생성하여 식중독을 일으킵니다. 다음은 C. perfringens가 식중독을 일으키는 방법에 대한 단계별 과정입니다.
1.오염: C. perfringens 박테리아는 토양, 물, 사람과 동물의 장에서 흔히 발견됩니다. 적절한 위생 관행을 따르지 않는 것과 같이 비위생적인 조건에서 식품을 준비하거나 취급하는 경우 C. perfringens에 오염될 위험이 더 높습니다.
2.증식: 오염된 식품을 C. perfringens의 성장에 이상적인 온도 범위인 20°C ~ 50°C(68°F ~ 122°F)의 온도에서 조리하고 보관하면 박테리아가 빠르게 증식하여 많은 수의 세포.
3.독소 생성: 박테리아가 증식함에 따라 C. perfringens enterotoxin(CPE)이라는 내열성 독소를 생성합니다. CPE는 C. perfringens의 A형 균주에 의해 생산되며 열, 위산 및 소화 효소에 저항성이 있어 소화 과정에서 살아남아 소장에 도달할 수 있습니다.
4.장 감염: 일단 섭취하면 CPE 독소는 소장의 세포에 결합하여 손상과 염증을 일으킵니다. 이것은 복부 경련, 설사 및 메스꺼움과 같은 C. perfringens 식중독의 특징적인 증상을 유발할 수 있습니다.
5.증상 발병: C. perfringens 식중독의 증상은 일반적으로 오염된 음식을 섭취한 후 6~24시간 이내에 나타나며 최대 24~48시간 동안 지속될 수 있습니다.
모든 C. perfringens 균주가 CPE 독소를 생산하는 것은 아니며 모든 C. perfringens 감염이 독소에 의해 유발되는 것은 아니라는 점에 유의하는 것이 중요합니다. 경우에 따라 감염은 박테리아 자체에 의해 발생하며, 이는 다른 일련의 증상을 유발할 수 있습니다.
4.클로스트리디움 퍼프린젠스 식중독 증상은?
클로스트리디움 퍼프린젠스 식중독의 증상은 보통 오염된 음식을 섭취한 후 6~24시간 이내에 나타나지만 나타나기까지 최대 48시간이 걸릴 수 있습니다. 증상은 경증에서 중증까지 다양하며 보통 24~48시간 동안 지속됩니다. C. 퍼프린젠스 식중독의 가장 흔한 증상은 다음과 같습니다.
1.복부 경련: C. perfringens 식중독의 가장 흔한 증상은 심각하고 고통스러울 수 있는 복부 경련입니다.
2.설사: C. perfringens 식중독의 또 다른 일반적인 증상은 설사로, 설사는 묽거나 피가 섞일 수 있으며 일반적으로 24시간 미만 동안 지속됩니다.
3.메스꺼움: 메스꺼움과 구토는 또한 C. perfringens 식중독의 일반적인 증상입니다.
4.열: 일부 사람들은 C. perfringens 식중독으로 미열이 발생할 수 있습니다.
5.탈수: 설사와 구토는 탈수로 이어질 수 있으며, 이는 구강 건조, 갈증, 소변량 감소와 같은 증상을 유발할 수 있습니다.
6.피로: 일부 사람들은 C. 퍼프린젠스 식중독으로 피로와 쇠약을 경험할 수 있습니다.
C. 퍼프린젠스 식중독의 증상은 살모넬라 또는 대장균 감염과 같은 다른 유형의 식중독 증상과 유사할 수 있다는 점에 유의하는 것이 중요합니다. 따라서 이러한 증상이 나타나면 특히 증상이 심하거나 며칠 이상 지속되는 경우 의사의 진료를 받는 것이 중요합니다.
5.클로스트리디움 퍼프린젠스 식중독은 어떻게 진단됩니까?
클로스트리디움 퍼프린젠스 식중독은 일반적으로 증상과 박테리아로 오염된 음식을 먹은 이력을 기반으로 진단됩니다. 그러나 진단을 확인하고 증상의 다른 원인을 배제하기 위해 추가 검사를 실시할 수 있습니다. 이러한 테스트에는 다음이 포함됩니다.
1.대변 배양: 대변에 C. perfringens가 있는지 확인하기 위해 대변 배양을 실시할 수 있습니다. 여기에는 대변 샘플을 수집하여 검사를 위해 실험실로 보내는 것이 포함됩니다.
2.혈액 검사: 감염을 나타낼 수 있는 혈류 내 C. 퍼프린젠스에 대한 항체의 존재를 확인하기 위해 혈액 검사를 실시할 수 있습니다.
3.PCR 검사: 대변 검체에서 C. perfringens DNA의 존재를 검출하기 위해 중합효소 연쇄 반응(PCR) 검사를 실시할 수 있습니다.
특히 증상이 경미하고 며칠 내에 저절로 해결되는 경우 이러한 검사가 항상 필요한 것은 아니라는 점에 유의하는 것이 중요합니다. 그러나 증상이 심하거나 며칠 이상 지속되면 평가 및 검사를 위해 의료 서비스 제공자를 만나는 것이 중요합니다. 경우에 따라 탈수 또는 심한 복통과 같은 합병증으로 치료를 위해 입원이 필요할 수 있습니다.
6.클로스트리디움 퍼프린젠스 식중독은 어떻게 치료하나요?
대부분의 클로스트리디움 퍼프린젠스 식중독 사례는 24~48시간 이내에 저절로 해결되며 치료가 필요하지 않습니다. 그러나 경우에 따라 증상을 관리하고 합병증을 예방하기 위해 치료가 필요할 수 있습니다. C. 퍼프린젠스 식중독에 대한 치료 옵션은 다음과 같습니다.
1.수분 보충: 치료의 가장 중요한 측면은 설사와 구토로 인해 발생할 수 있는 탈수를 예방하는 것입니다. 물, 스포츠 음료 또는 구강 재수화 용액과 같은 수분을 충분히 섭취하면 손실된 수분과 전해질을 보충하는 데 도움이 될 수 있습니다.
2.약물: 로페라미드와 같은 지사제는 설사를 조절하는 데 사용할 수 있지만, 박테리아를 제거하는 신체의 능력을 늦출 수 있으므로 주의해서 사용해야 합니다.
3.항생제: C. perfringens 식중독 치료에 항생제는 일상적으로 사용되지 않습니다. 감염은 일반적으로 자가 제한적이며 항생제가 항생제 내성 박테리아의 성장을 촉진할 수 있기 때문입니다. 그러나 심한 경우 메트로니다졸 또는 반코마이신과 같은 항생제를 사용하여 감염을 치료할 수 있습니다.
4.입원: 심한 C. perfringens 식중독의 경우 탈수 또는 심한 복통과 같은 합병증을 관리하기 위해 입원이 필요할 수 있습니다.
예방이 C. perfringens 식중독을 피하는 가장 좋은 방법이라는 점에 유의하는 것이 중요합니다. 손을 씻고 음식을 적절한 온도로 요리하는 것과 같은 적절한 음식 취급 및 위생 관행은 C. perfringens로 인한 오염을 방지하는 데 도움이 될 수 있습니다.
7.클로스트리디움 퍼프린젠스 식중독 예방

클로스트리디움 퍼프린젠스 식중독 예방에는 적절한 식품 취급, 보관 및 위생 관행이 포함됩니다. 다음은 씨. 퍼프린젠스 식중독을 예방하기 위한 몇 가지 주요 조치입니다.
1.적절한 식품 취급: 적절한 식품 취급은 C. perfringens로 인한 오염을 방지하는 데 필수적입니다. 여기에는 음식을 다루기 전과 후에 손을 철저히 씻는 것, 익히지 않은 음식과 익힌 음식을 위한 별도의 도마 사용, 교차 오염 방지가 포함됩니다.
2.음식을 완전히 익히기: 음식을 완전히 익히면 존재하는 모든 박테리아가 죽습니다. 식품 온도계를 사용하여 식품의 내부 온도가 가금류 및 남은 음식의 경우 최소 165°F(74°C), 다진 고기의 경우 160°F(71°C), 145°F(63°C)에 도달하는지 확인하십시오. 전체 고기 절단.
3.식품을 적절하게 보관하십시오: C. 퍼프린젠스를 포함한 박테리아의 성장을 방지하려면 식품을 적절하게 보관하는 것이 필수적입니다. 조리된 음식은 41°F(5°C) 이하 또는 140°F(60°C) 이상의 온도에서 보관하여 박테리아의 번식을 방지하십시오. 식품을 상온에 2시간 이상 보관하지 마십시오.
4.남은 음식을 적절하게 재가열: 남은 음식을 재가열할 때 내부 온도가 최소 165°F(74°C)에 도달하여 존재하는 모든 박테리아를 죽이십시오.
5.좋은 위생 습관을 유지하십시오: 좋은 위생 습관은 박테리아의 확산을 방지하는 데 필수적입니다. 비누와 물로 손을 자주 씻으십시오. 특히 화장실 사용, 기저귀 교체, 애완동물 만진 후에는 더욱 그렇습니다.
6.고위험 식품 피하기 : 상온에 장시간 방치한 익힌 고기나 대량으로 조리하여 장기간 방치한 식품 등 C. perfringens에 오염될 가능성이 높은 식품 섭취를 피한다. 미문.
이러한 관행을 따르면 C. perfringens 식중독 발병 위험을 크게 줄일 수 있습니다. 오염된 식품에 노출된 것으로 의심되는 경우 증상이 나타나면, 특히 증상이 심하거나 며칠 이상 지속되는 경우 의사의 진료를 받는 것이 중요합니다.
결론
클로스트리디움 퍼프린젠스 식중독은 심각한 위장 증상을 유발할 수 있는 흔한 식중독입니다. 장기간 상온에 방치된 오염된 식품을 섭취함으로써 발생합니다. 올바른 식품 취급 및 조리 방식은 클로스트리디움 퍼프린젠스 박테리아의 성장과 독소 생산을 예방할 수 있습니다. Clostridium perfringens 식중독 증상이 나타나면 탈수 및 전해질 불균형과 같은 합병증을 예방하기 위해 즉시 치료를 받으십시오.
'생활정보' 카테고리의 다른 글
| 조갑주위염: 원인, 증상, 치료 및 예방 (0) | 2023.03.29 |
|---|---|
| "고슴도치 딜레마: 친밀감과 고립의 역설" (1) | 2023.03.26 |
| 색소성 망막염: 원인, 증상, 진단, 치료 및 관리 (1) | 2023.03.25 |
| 사회의 타오르는 플레이밍(flaming) : 온라인 플레이밍(flaming)의 피해 효과 (0) | 2023.03.25 |
| 알츠하이머병이 눈에 어떻게 나타나는가 (0) | 2023.03.25 |